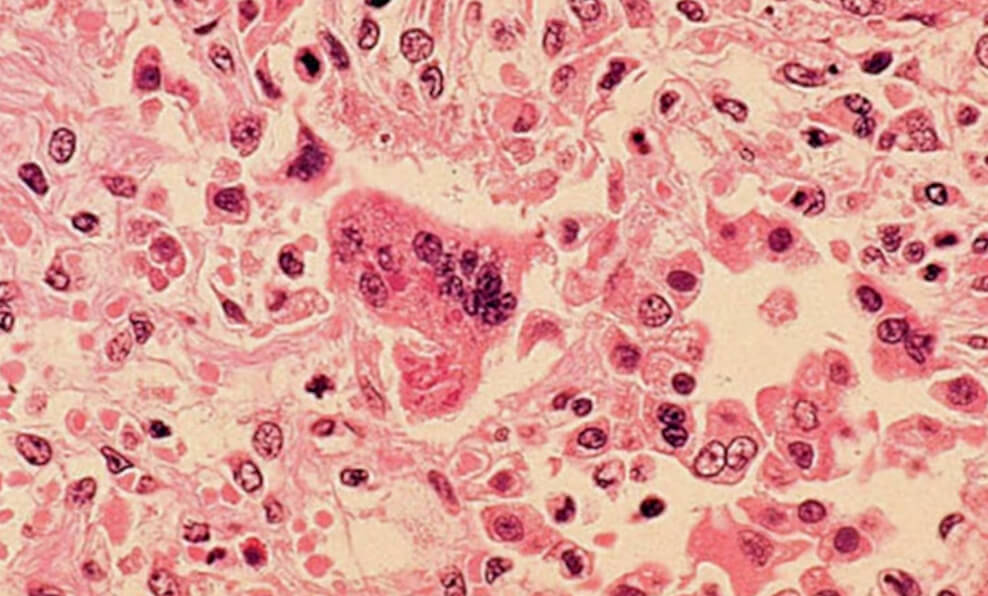

വിനിപെഗ് : മാനിറ്റോബയിലെ നിരവധി നഗരങ്ങളിൽ അഞ്ചാംപനി പടർന്നു പിടിക്കുന്നതായി മാനിറ്റോബ ആരോഗ്യ ഉദ്യോഗസ്ഥർ പൊതുജനങ്ങൾക്ക് മുന്നറിയിപ്പ് നൽകി. കഴിഞ്ഞ ആറ് ദിവസത്തിനുള്ളിൽ മൂന്ന് പുതിയ സ്ഥലങ്ങളിൽ അഞ്ചാംപനി അണുബാധ കണ്ടെത്തിയിട്ടുണ്ടെന്നും അധികൃതർ അറിയിച്ചു. മാനിറ്റോബയിൽ ഇതുവരെ 215 സ്ഥിരീകരിച്ചതും 22 സാധ്യതയുള്ളതുമായ അഞ്ചാംപനി കേസുകൾ റിപ്പോർട്ട് ചെയ്തിട്ടുണ്ട്. അഞ്ചാംപനി, സമ്പർക്ക സ്ഥലങ്ങൾ, വാക്സിനേഷനുകൾ എന്നിവയെക്കുറിച്ചുള്ള കൂടുതൽ വിവരങ്ങൾ പ്രവിശ്യയുടെ വെബ്സൈറ്റിൽ ലഭ്യമാണ്.

ഫെബ്രുവരി 28 ന് വൈകുന്നേരം നാല് മുതൽ ഏഴു വരെ നീപാവ ഹെൽത്ത് സെന്ററിന്റെ എമർജൻസി ഡിപ്പാർട്ട്മെൻ്റിലും മാർച്ച് 1 ന് രാവിലെ ഒമ്പതര മുതൽ ഉച്ചയ്ക്ക് ഒന്നര വരെ ആൾട്ടോണയിലെ ടെൻത്ത് കോമൺ ഏരിയയിലെ ദി ഗാർഡൻസിലെ അപ്പാർട്ടുമെൻ്റ്, മാർച്ച് 1 ന് രാവിലെ പത്തര മുതൽ ഉച്ചക്ക് ഒന്നര വരെ ആൾട്ടോണ സോമർഫീൽഡ് മെന്നോണൈറ്റ് ചർച്ച് എന്നിവിടങ്ങളിൽ അഞ്ചാംപനി അണുബാധയ്ക്ക് സാധ്യതയുണ്ടെന്ന് ആരോഗ്യവകുപ്പ് അറിയിച്ചു. ഈ സമയങ്ങളിൽ ഈ സ്ഥലങ്ങൾ സന്ദർശിച്ചവർ മീസിൽസ് വാക്സിൻ എടുത്തിട്ടുണ്ടോ എന്ന് പരിശോധിക്കണം. വാക്സിൻ എടുത്തിട്ടില്ലാത്തവർ അഞ്ചാംപനി ലക്ഷണങ്ങൾ പരിശോധിക്കണം. അഞ്ചാംപനി ബാധിച്ച് ഏഴ് മുതൽ 21 ദിവസങ്ങൾക്കുള്ളിൽ ലക്ഷണങ്ങൾ പ്രത്യക്ഷപ്പെടും. പനി, മൂക്കൊലിപ്പ്, കണ്ണുകൾക്ക് ചുവപ്പ് നിറം എന്നീ ലക്ഷണങ്ങളോടെയാണ് അഞ്ചാംപനി ആരംഭിക്കുന്നത്. വായയുടെ ഉള്ളിൽ വെളുത്ത പാടുകളും ഉണ്ടാകാം. പ്രാരംഭ ലക്ഷണങ്ങളെ തുടർന്ന്, മുഖത്ത് സാധാരണയായി ചുവന്ന പാടുകളുള്ള ഒരു ചുണങ്ങു പ്രത്യക്ഷപ്പെടുകയും ശരീരത്തിലുടനീളം പടരുകയും ചെയ്യും.